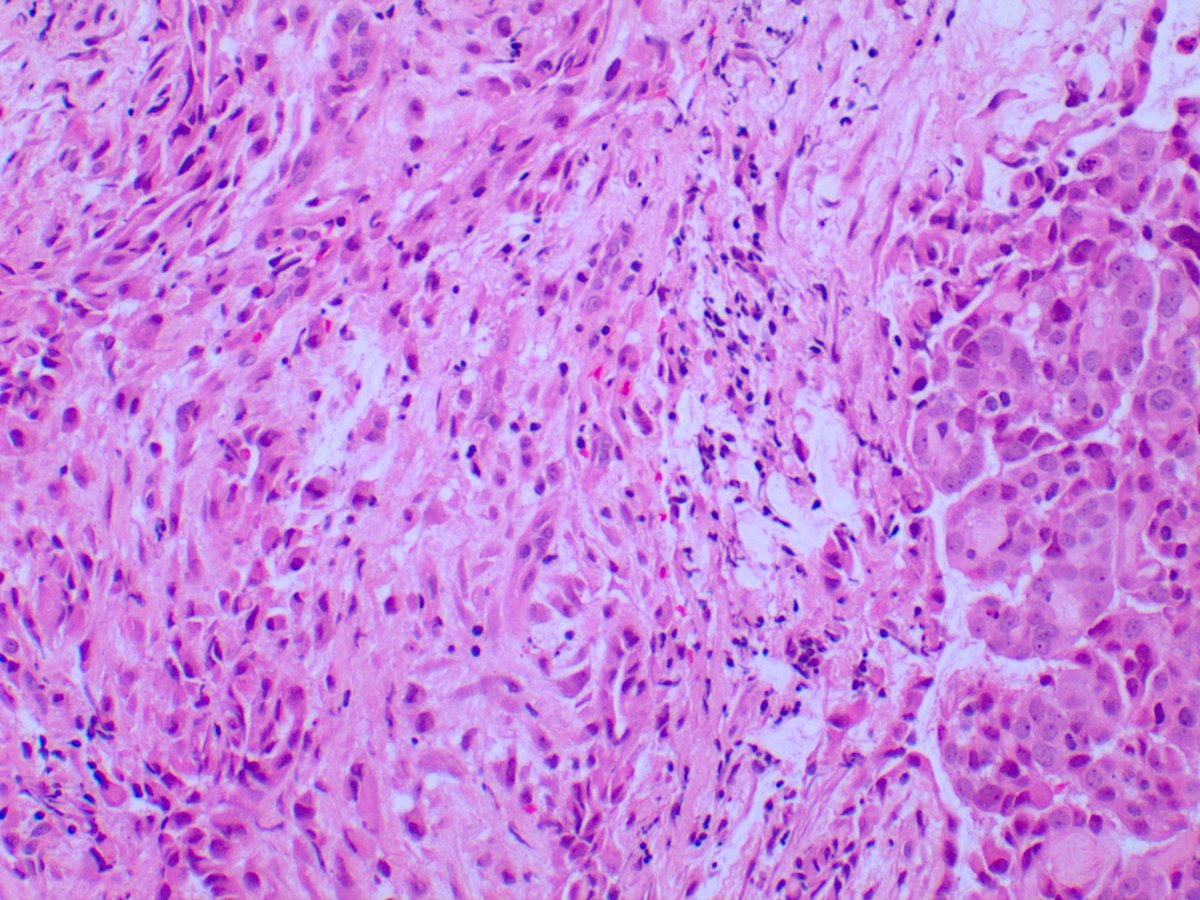
4. Getting back on track, our little lady in question two was married to this 74-year-old male, who also dabbled with asbestos sculptures in his garage. He too presents with a pleural rind.

How about some pleural lesion #pulmpath?
1/5 #tweetorial on thoracic #spindlythings
1. To get warmed up, let's start with a 43-year-old female, presenting with a peripheral lung mass
1/5 #tweetorial on thoracic #spindlythings
1. To get warmed up, let's start with a 43-year-old female, presenting with a peripheral lung mass
Biopsy shows the so-called "patternless pattern" of spindle cells with a hemangiopericytic growth pattern. These tumors are thought to arise from which of the following cell types?
Mesenchymal, probably fibroblastic; and yes, you guessed it...this is a Solitary Fibrous Tumor (STF). SFTs can be found almost anywhere but intra-thoracic is the most common location. Pleura-based is the most common location within the thoracic cavity. Clinching stain is STAT6
What is the top of your differential?
Turns out this awesome little lady worked around shipyards her whole life...so mesothelioma jumps to the top of the list. How would you stain this tumor to highlight the malignant mesothelial cells?
CK5/6 is typically expressed in epithelioid mesothelioma but can be negative in sarcomatous mesothelioma.
3. And I know this doesn't quite fit the 'pleural lesions' theme, but how about this 64-year-old male presenting with a pulmonary embolus after a heart transplant.
This lesion was first described by the late, great Rosai in 1997 who called this particular lesion a "histiocytoid hemangioma." Since that time, Cedars very own Dr. Luthringer published 14 cases and suggested which other cell type is present?
As the name suggests: mesothelial/monocytic incidental cardiac excrescences (cardiac MICE) is a rare lesion composed of reactive mesothelial cells and histocytes all bundled neatly together. Most cases are identified incidentally and have a benign course.
4. Getting back on track, our little lady in question two was married to this 74-year-old male, who also dabbled with asbestos sculptures in his garage. He too presents with a pleural rind.
This time, we have two components - epithelioid and sarcomatous. Typically, CK5/6 should not stain the sarcomatous portion of the tumor [not done, unfortunately]. WT1 and Calretinin are shown here.
If present, which of the following mutation are specific for mesothelioma?
BAP1 and MTAP, if present, are 100% specific for mesothelioma. Another good one to remember is homozygous deletion of CDKN2A (p16).
5. Finally, we have a peripheral lung lesion in a 54-year-old female with a history of breast cancer.
Not exactly classic, but for the sake of argument, hemorrhage and hemosiderin were abundant in other sections. CD31 highlights the vascular etiology of this lesion.
Angiosarcoma. What genomic amplification is associated with angiosarc?
MYC! Thank you for joining me on this little journey. Any additional cases, comments, previous tweetorials, or additional information is always welcome :)
#pathology #mesothelioma #sft #pleura #angiosarcoma
#pathology #mesothelioma #sft #pleura #angiosarcoma

 Read on Twitter
Read on Twitter

![This time, we have two components - epithelioid and sarcomatous. Typically, CK5/6 should not stain the sarcomatous portion of the tumor [not done, unfortunately]. WT1 and Calretinin are shown here. This time, we have two components - epithelioid and sarcomatous. Typically, CK5/6 should not stain the sarcomatous portion of the tumor [not done, unfortunately]. WT1 and Calretinin are shown here.](https://pbs.twimg.com/media/Eoa_d_9VgAEpLQQ.jpg)
![This time, we have two components - epithelioid and sarcomatous. Typically, CK5/6 should not stain the sarcomatous portion of the tumor [not done, unfortunately]. WT1 and Calretinin are shown here. This time, we have two components - epithelioid and sarcomatous. Typically, CK5/6 should not stain the sarcomatous portion of the tumor [not done, unfortunately]. WT1 and Calretinin are shown here.](https://pbs.twimg.com/media/Eoa_f2NU0AEmw_I.jpg)






